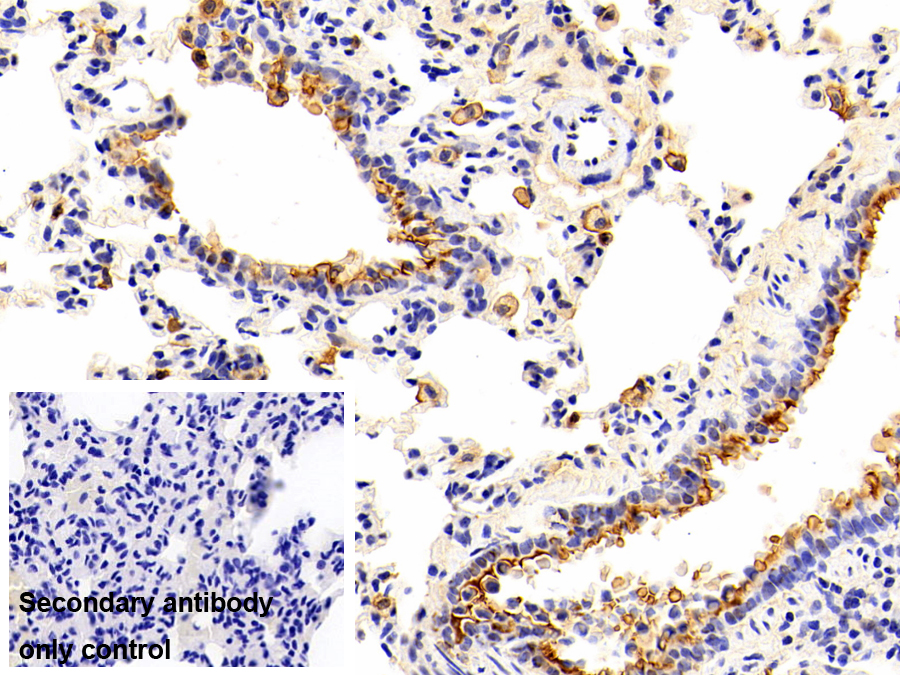
Monoclonal Antibody to Annexin A1 (ANXA1)

Monoclonal Antibody to Annexin A1 (ANXA1)
ANX-A1; ANX1; LPC1; Lipocortin I; Chromobindin-9; Calpactin II; Phospholipase A2 inhibitory protein
- Product No.MAE787Hu24
- Organism SpeciesHomo sapiens (Human) Same name, Different species.
- SourceMonoclonal antibody preparation
- HostMouse
- Potency (Clone Number)D10
- Ig Isotype IgG
- PurificationAntigen-specific affinity chromatography followed by Protein A affinity chromatography
- LabelNone
- Immunogen n/a
- Buffer FormulationPBS, pH7.4, containing 0.02% NaN3, 50% glycerol.
- TraitsLiquid
- Concentration1mg/mL
- Organism Species MoreRattus norvegicus (Rat)
- ApplicationsIHC
If the antibody is used in flow cytometry, please check FCM antibodies. - Downloadn/a
- UOM 20µl100µl 200µl 1ml 10ml
- FOB
US$
US$
US$
US$
US$
For more details, please contact local distributors!
SPECIFITY
The antibody is a mouse monoclonal antibody raised against ANXA1. It has been selected for its ability to recognize ANXA1 in immunohistochemical staining and western blotting.
USAGE
Western blotting: 0.1-2µg/mL;
Immunohistochemistry: 5-20µg/mL;
Immunocytochemistry: 5-20µg/mL;
Optimal working dilutions must be determined by end user.
STORAGE
Store at 4°C for frequent use. Stored at -20°C in a manual defrost freezer for two year without detectable loss of activity. Avoid repeated freeze-thaw cycles.
STABILITY
The thermal stability is described by the loss rate. The loss rate was determined by accelerated thermal degradation test, that is, incubate the protein at 37°C for 48h, and no obvious degradation and precipitation were observed. The loss rate is less than 5% within the expiration date under appropriate storage condition.
GIVEAWAYS
INCREMENT SERVICES
-
 Antibody Labeling Customized Service
Antibody Labeling Customized Service
-
 Protein A/G Purification Column
Protein A/G Purification Column
-
 Staining Solution for Cells and Tissue
Staining Solution for Cells and Tissue
-
 Positive Control for Antibody
Positive Control for Antibody
-
 Tissue/Sections Customized Service
Tissue/Sections Customized Service
-
 Phosphorylated Antibody Customized Service
Phosphorylated Antibody Customized Service
-
 Western Blot (WB) Experiment Service
Western Blot (WB) Experiment Service
-
 Immunohistochemistry (IHC) Experiment Service
Immunohistochemistry (IHC) Experiment Service
-
 Immunocytochemistry (ICC) Experiment Service
Immunocytochemistry (ICC) Experiment Service
-
 Flow Cytometry (FCM) Experiment Service
Flow Cytometry (FCM) Experiment Service
-
 Immunoprecipitation (IP) Experiment Service
Immunoprecipitation (IP) Experiment Service
-
 Immunofluorescence (IF) Experiment Service
Immunofluorescence (IF) Experiment Service
-
 Buffer
Buffer
-
 DAB Chromogen Kit
DAB Chromogen Kit
-
 SABC Kit
SABC Kit
-
 Long-arm Biotin Labeling Kit
Long-arm Biotin Labeling Kit
-
 Real Time PCR Experimental Service
Real Time PCR Experimental Service
| Magazine | Citations |
| Plos one | Dysregulation of Anti-Inflammatory Annexin A1 Expression in Progressive Crohns Disease PubMed: PMC3794972 |
| African Journals Online | Modulatory Effect of Phytoestrogens and Curcumin on Induction of Annexin 1 in Human Peripheral Blood Mononuclear Cells and their Inhibitory Effect on Secretory Phospholipase A2 Ajol: Source |
| Antimicrobial Agents and Chemotherapy | Host Biomarkers of Invasive Pulmonary Aspergillosis to Monitor Therapeutic Response Asm: Source |
| J Proteomics | Characterization of secretomes from a human blood brain barrier endothelial cells in-vitro model after ischemia by stable isotope labeling with aminoacids in cell culture (SILAC) PubMed: 26718731 |
| Diabetes | Annexin A1 Is a Key Modulator of Mesenchymal Stromal Cell–Mediated Improvements in Islet Function PubMed: 26470781 |
| PLoS One | Annexin A1 Is Increased in the Plasma of Preeclamptic Women PubMed: 26398190 |
| 中国现代医学杂志 China Journal of Modern Medicine | 膜联蛋白A1 和CA19-9 在胆管癌中的表达及其临床意义 article:8686 |
| arteriosclerosis thrombosis and vascular biology | Protective Aptitude of Annexin A1 in Arterial Neointima Formation in Atherosclerosis-Prone Mice-Brief Report. pubmed:28062503 |
| Clinical Science | Mesenchymal stromal cells improve human islet function through released products and extracellular matrix. pubmed:29101297 |
| Biomedicine & Pharmacotherapy | Proresolving protein Annexin A1: The role in type 2 diabetes mellitus and obesity Pubmed:29677533 |
| International Journal of Chronic Obstructive Pulmonary Disease | Annexin A1 is elevated in patients with COPD and affects lung fibroblast function Pubmed:29440885 |
| Medical Mycology | Applying host disease status biomarkers to therapeutic response monitoring in invasive aspergillosis patients Pubmed:29370415 |
| DEVELOPMENTAL NEUROPSYCHOLOGY | EFFECTS OF MULTICOMPONENT EXERCISE ON PROGRESSION OF BRAIN ATROPHY AND COGNITION IN AMNESTIC MILD COGNITIVE IMPAIRMENT … pdf:3395 |
| Multiple sclerosis and related disorders | Resolution of inflammation in neuromyelitis optica spectrum disorders Pubmed: 30300851 |
| Acta Pharmaceutica | Effects of annexin A1 on apoptosis and cell cycle arrest in human leukemic cell lines |
| npj Science of Food | Annexin A1 accounts for an anti-inflammatory binding target of sesamin metabolites Pubmed: 32133417 |
| FASEB JOURNAL | ANXA1 directs Schwann cells proliferation and migration to accelerate nerve regeneration through the FPR2/AMPK pathway Pubmed: 32908567 |
| Rev Soc Bras Med Trop | Expression of annexin-A1 in blood and tissue leukocytes of leprosy patients 33263684 |
| science advances | Annexin-A1 SUMOylation regulates microglial polarization after cerebral ischemia by modulating IKK¦Á stability via selective autophagy 33523920 |